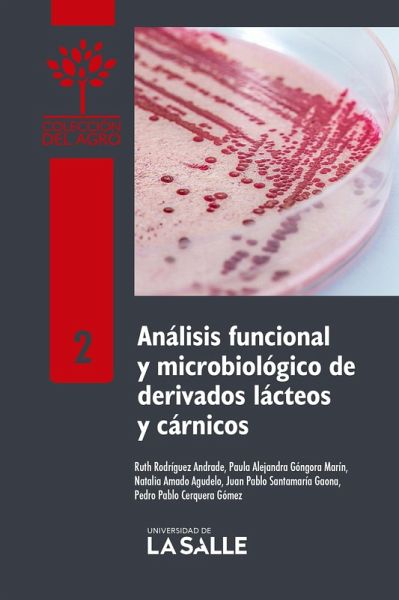

Análisis funcional y microbiológico de derivados lácteos y cárnicos (eBook, PDF)
PAYBACK Punkte
0 °P sammeln!
Contar con un estricto control de las materias primas y derivados lácteos y cárnicos es indispensable para proteger la salud de los consumidores; por ello, la zootecnia es uno de los eslabones que contribuye a la seguridad alimentaria mundial.En ese sentido, el presente texto le permite al futuro zootecnista identificar los procedimientos básicos a desarrollar con las carnes frescas tanto para conocer sus propiedades funcionales como para hacer un análisis microbiológico que permita asegurar el cumplimiento de la normativa legal vigente en Colombia. La obra presenta además generalidades ...
Contar con un estricto control de las materias primas y derivados lácteos y cárnicos es indispensable para proteger la salud de los consumidores; por ello, la zootecnia es uno de los eslabones que contribuye a la seguridad alimentaria mundial.En ese sentido, el presente texto le permite al futuro zootecnista identificar los procedimientos básicos a desarrollar con las carnes frescas tanto para conocer sus propiedades funcionales como para hacer un análisis microbiológico que permita asegurar el cumplimiento de la normativa legal vigente en Colombia. La obra presenta además generalidades de microbiología, medios de cultivos recomendados y las formas visuales de los microorganismos contaminantes en estos alimentos; por último, describe cómo determinar la capacidad de retención de agua, el poder emulsificante y pH claves en la obtención de derivados cárnicos de calidad.
Dieser Download kann aus rechtlichen Gründen nur mit Rechnungsadresse in A, B, BG, CY, CZ, D, DK, EW, E, FIN, F, GR, H, IRL, I, LT, L, LR, M, NL, PL, P, R, S, SLO, SK ausgeliefert werden.